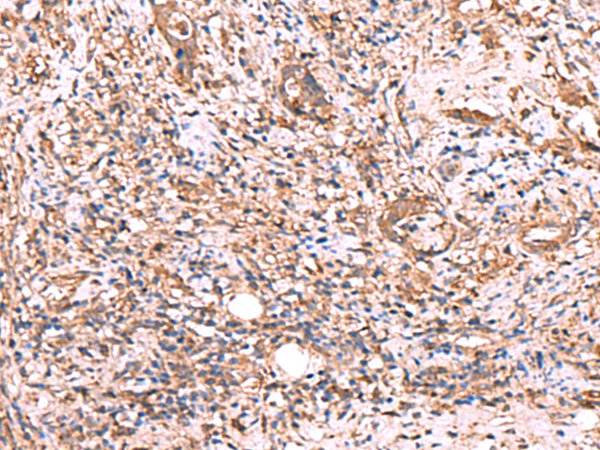

|
Background: |
TTC38 (tetratricopeptide repeat domain 38) is a 469 amino acid protein that contains three TPR repeats and belongs to the TTC38 family. The gene that encodes TTC38 consists of over 26,000 bases and maps to 22q13. Housing over 500 genes, chromosome 22 is the second smallest chromosome in the human genome. Mutations in several of the genes that map to chromosome 22 are involved in the development of Phelan-McDermid syndrome, Neurofibromatosis type 2, autism and schizophrenia. In addition, translocations between chromosomes 9 and 22 may lead to the formation of the Philadelphia Chromosome and the subsequent production of the novel fusion protein BCR-Abl, a potent cell proliferation activator found in several types of leukemias. |
|
Applications: |
ELISA, IHC |
|
Name of antibody: |
TTC38 |
|
Immunogen: |
Fusion protein of human TTC38 |
|
Full name: |
tetratricopeptide repeat domain 38 |
|
Synonyms: |
LL22NC03-5H6.5 |
|
SwissProt: |
Q5R3I4 |
|
ELISA Recommended dilution: |
5000-10000 |
|
IHC positive control: |
Human tonsil and Human cervical cancer |
|
IHC Recommend dilution: |
50-300 |

購物車
購物車 幫助
幫助
 021-54845833/15800441009
021-54845833/15800441009
